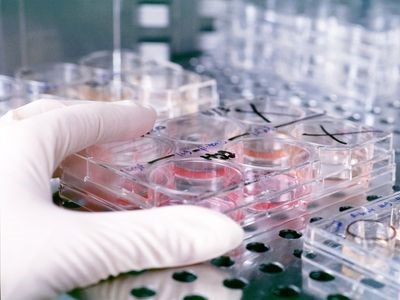

Kristýna Gaurová
Vánoce jsou tady!
 Taky už jste za poslední dobu tolikrát slyšeli větu „Musím jít do obchodu koupit všechny ty vánoční dárky, ale hrozně se mi nechce.“? Já ji slyším snad ze všech stran od kamarádů, sourozenců i od úplně cizích lidí, kteří procházejí kolem mě na ulici. Ne, že bych odposlouchávala cizí rozhovory, jen jsem se na to trochu více zaměřila.
Taky už jste za poslední dobu tolikrát slyšeli větu „Musím jít do obchodu koupit všechny ty vánoční dárky, ale hrozně se mi nechce.“? Já ji slyším snad ze všech stran od kamarádů, sourozenců i od úplně cizích lidí, kteří procházejí kolem mě na ulici. Ne, že bych odposlouchávala cizí rozhovory, jen jsem se na to trochu více zaměřila.
Skříňkový betlém z 19. století
 Zpátky do minulosti se můžete podívat, když si uděláte procházku až k dómu. Právě v těchto dnech je zde, v olomouckém Arcidiecézním muzeu, k vidění skříňkový betlém až z 19. století. Tento vytvořil slezský výrobce betlémů Josef Partsch, který byl jedním z nejznámějších a nejvíce žádaných řezbářů své doby.
Zpátky do minulosti se můžete podívat, když si uděláte procházku až k dómu. Právě v těchto dnech je zde, v olomouckém Arcidiecézním muzeu, k vidění skříňkový betlém až z 19. století. Tento vytvořil slezský výrobce betlémů Josef Partsch, který byl jedním z nejznámějších a nejvíce žádaných řezbářů své doby.
A kdy to skončí?
I přesto, že lidí s akutním onemocněním horních cest dýchacích v posledních dnech ubylo, lékaři varují, že nebezpečí prasečí chřipky je stále mezi námi. Laboratoře potvrdily, že počet pacientů nakažených prasečí chřipkou v Olomouckém kraji pořád roste. A to jen těch, u kterých tato nemoc byla již zjištěna. Skutečnost může být daleko horší.
I přesto, že lidí s akutním onemocněním horních cest dýchacích v posledních dnech ubylo, lékaři varují, že nebezpečí prasečí chřipky je stále mezi námi. Laboratoře potvrdily, že počet pacientů nakažených prasečí chřipkou v Olomouckém kraji pořád roste. A to jen těch, u kterých tato nemoc byla již zjištěna. Skutečnost může být daleko horší.
Vánoční strom na náměstí
Včerejší podvečer se nesl v duchu Vánoc. Na Horním náměstí byl totiž vztyčen vánoční strom pro Olomouc. Ten letošní vypěstovali žáci Gymnázia Čajkovského přímo na svém školním pozemku. O tom, že tento Smrk ztepilý se stane symbolem letošních vánočních svátků v Olomouci, rozhodli radní, o tom, jak se bude jmenovat, můžete rozhodnou i vy. Z návrhů občanů se opět vybere ten nejvhodnější. Do konce listopadu jsou přijímány na emailové adrese
Slavnostní rozsvícení stromu se pak bude konat v sobotu 5. prosince od 18. hodiny.
Pojďme vzpomínat…
Druhý listopadový den má svátek... Nikdo svátek nemá. Druhý listopad je totiž v kalendáři zaznamenán jako Památka zesnulých.
Santa v říjnu!
Zrovna včera jsem jela kolem domu, na který postarší pán věšel spousty světýlek a na zahradě měl postavené sáně a soby. Ne, to opravdu není scéna z amerického filmu, ale skutečnost, že Vánoční svátky jsou za necelé dva měsíce tady. A letos ve stylu Nového světa víc než obvykle…
- 1
- 2
O portálu
Zpravodajsko-publicistický portál Pres.UPmedia.cz je cvičným médiem, prostorem pro tvorbu studentů oboru Žurnalistika na Katedře mediálních a kulturálních studií a žurnalistiky Filozofické fakulty Univerzity Palackého v Olomouci.




